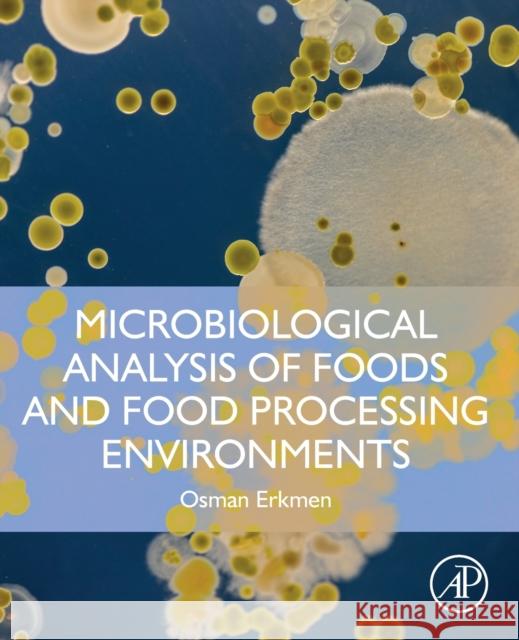
Microbiological Analysis of Foods and Food Processing Environments Osman Erkmen 9780323916516 Academic Press - książka

Microbiological Analysis of Foods and Food Processing Environments » książka
topmenu
Microbiological Analysis of Foods and Food Processing Environments
ISBN-13: 9780323916516 / Angielski / Miękka / 2021 / 602 str.
Kategorie:
Kategorie BISAC:
Wydawca:
Academic Press
Język:
Angielski
ISBN-13:
9780323916516
Rok wydania:
2021
Ilość stron:
602
Waga:
1.01 kg
Wymiary:
23.5 x 19.05 x 3.1
Oprawa:
Miękka
Wolumenów:
01